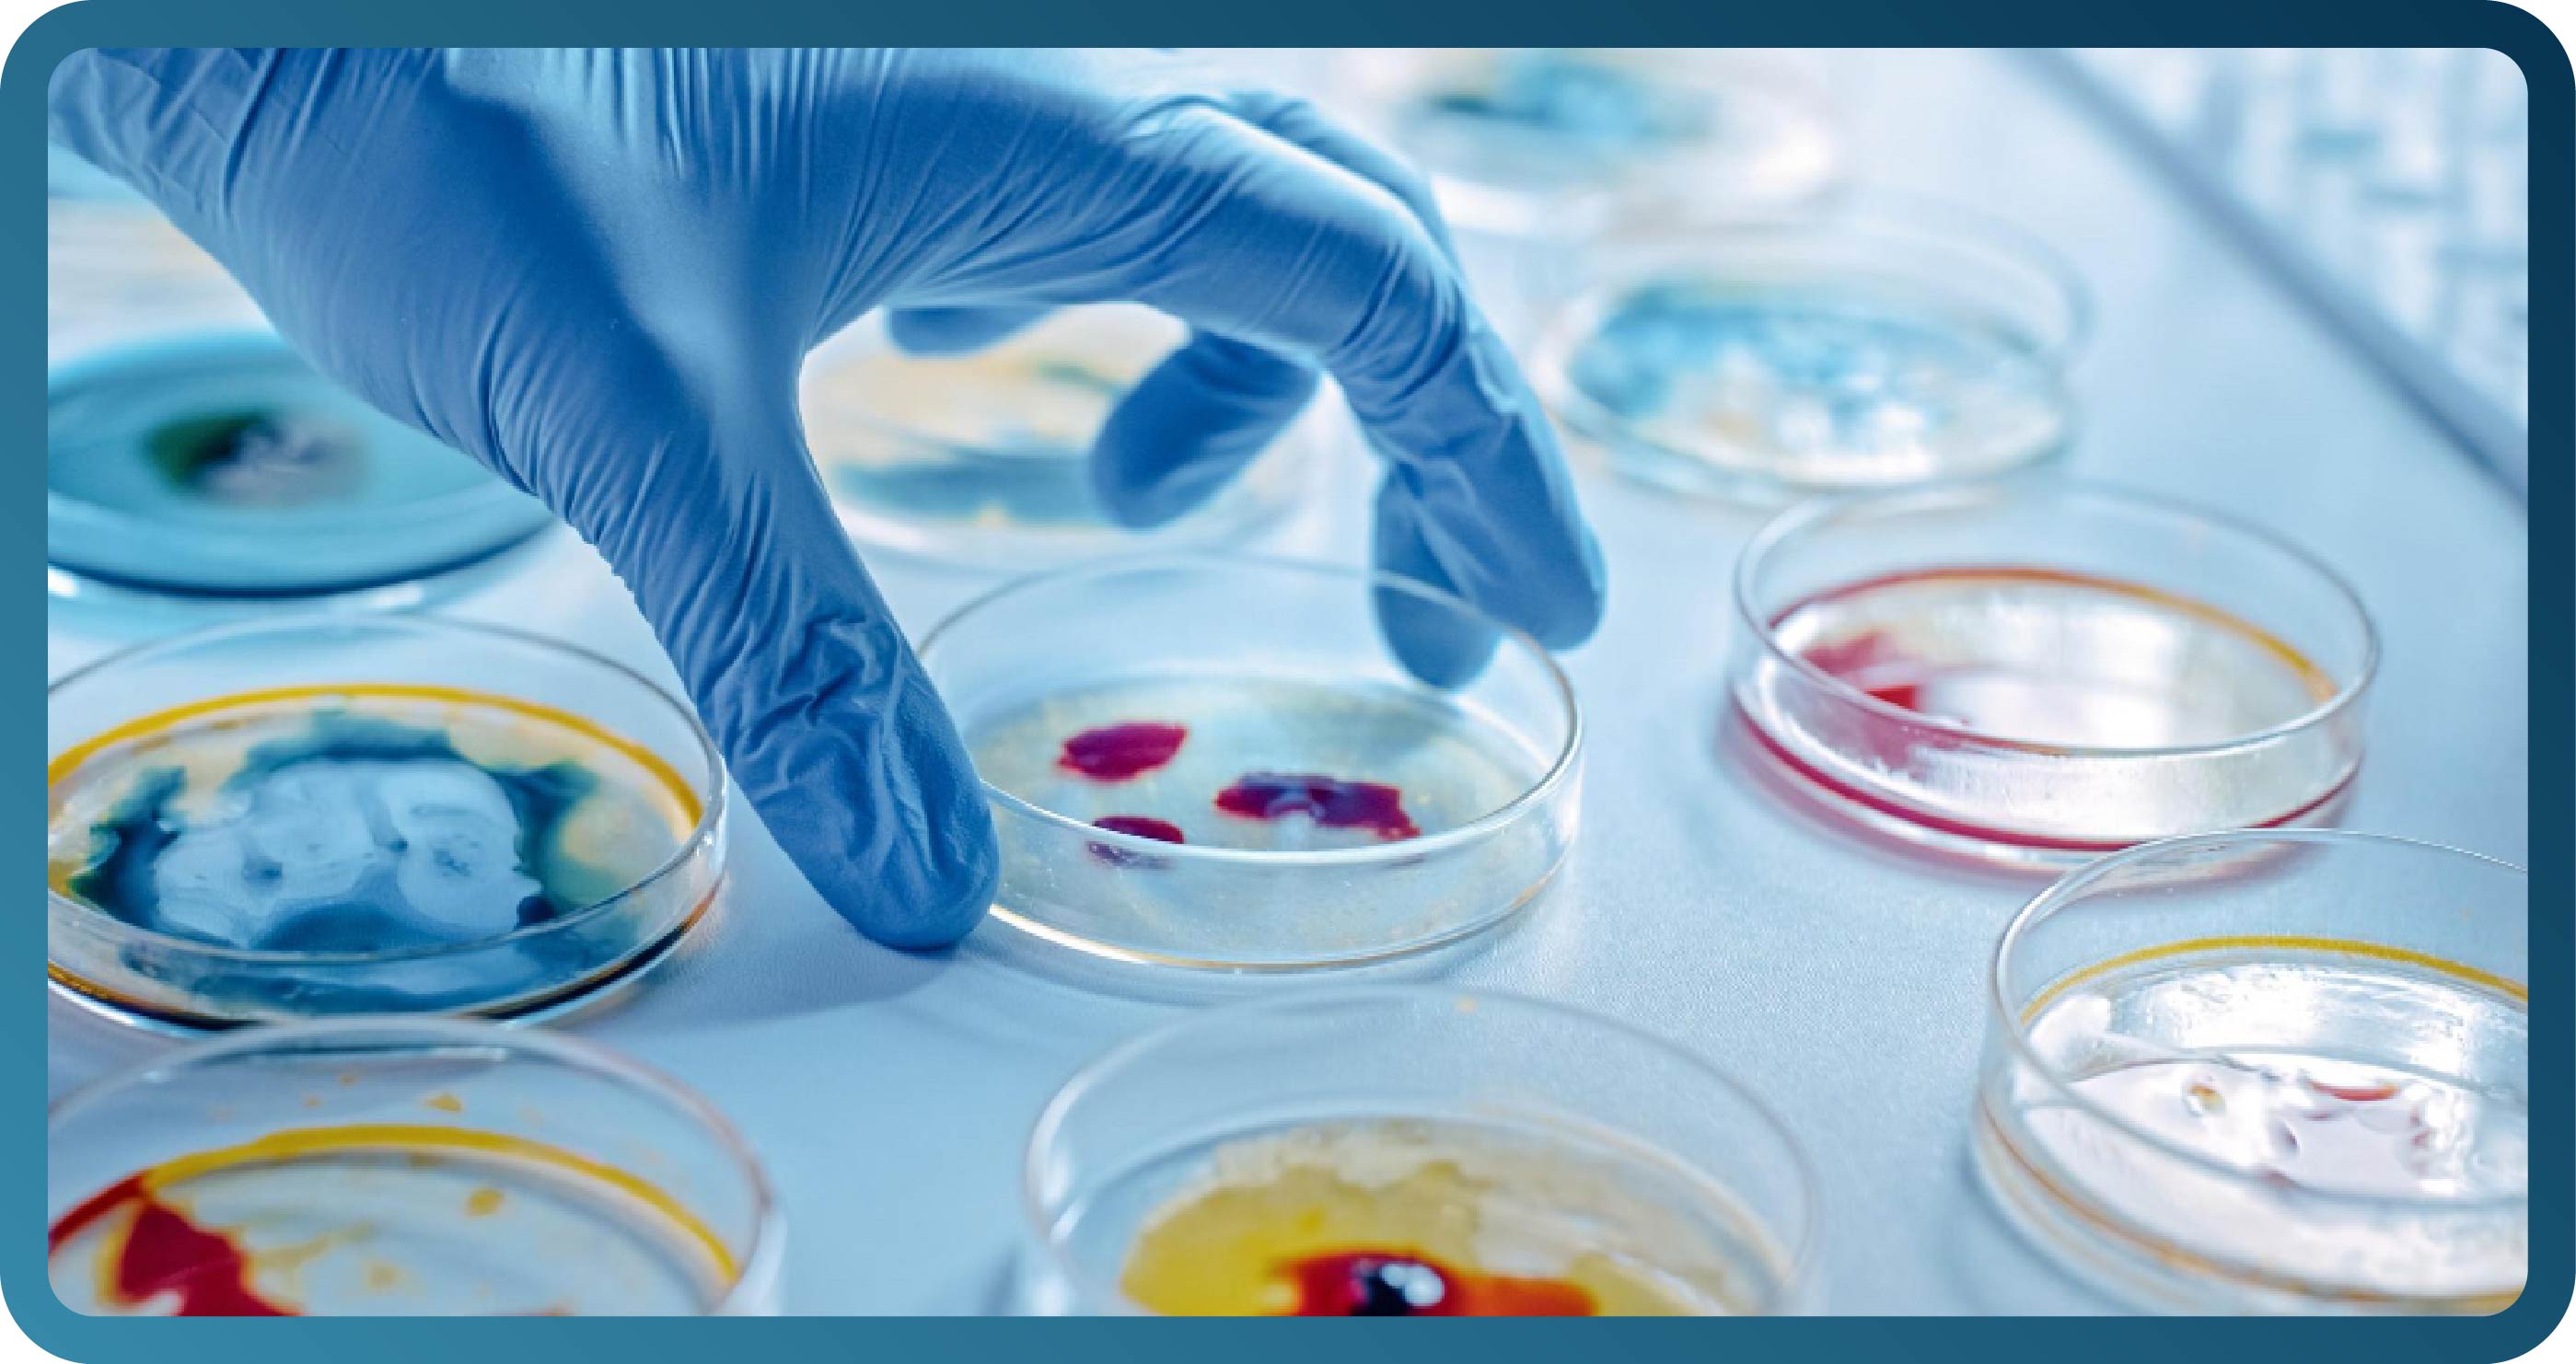

- PRIVACY POLICY
SMS Global Medical Solutions, Inc. and its parent company SMS Global Technologies, Inc. (collectively, “SMSGMS”, “we”, “us”, “our”) regard your privacy rights under law with utmost importance. This Privacy
Policy and User Terms and Conditions (“Privacy Policy”) outlines our policy in relation to the collection, processing, use, and protection of your User Data (defined below) to provide you with a secure user
experience. From time to time, we may update our Privacy Policy to reflect current changes in our policy and the law. When we do so, we will notify you by posting it on our website for your information and
reference.
- YOUR RIGHTS AS A USER
SMSGMS recognizes that you should be the ultimate decision-maker on matters that involve your personal or sensitive personal information, as defined under Republic Act No. 10173, or the Data Privacy Act of
2012, including its implementing rules and regulations, and issuances of the National Privacy Commission in relation thereto (“DPA”), and further described below (“Personal Information”).
By clicking “I accept the Privacy Policy and User Terms and Conditions” or accepting the terms of any agreement or document to which this Privacy Policy is attached, you agree to the collection, processing,
use, and sharing of your Personal Information in accordance with this Privacy Policy that will enable us to use the User Data provided in order to fulfill the purposes outlined in the website.
You have the right to be informed of the Personal Information that we collect, process, use, and share. We can provide you with such Personal Information, provided that such Personal Information does not
amount to information deemed confidential or proprietary by SMSGMS, or that your request for Personal Information is not unlawful, vexatious or unreasonable.
You have the right to object or withhold your consent to the collection, processing, use, and sharing of your Personal Information. However, we may be constrained to terminate your ability to use the website
or other SMSGMS service as your Personal Information may be required for such use or delivery of service. Without your Personal Information, we will be unable to provide you with updates; similarly, you will
be unable to participate in our events, promotions, or other activities.
You have the right to suspend, withdraw, or order the blocking, removal, or destruction of your Personal Information in our processing systems upon discovery and substantial proof that your Personal
Information is no longer necessary for the purpose or purposes for which it was collected, and for such other cases provided in the DPA.
You have the right to seek indemnity for damages sustained, if any, due to inaccurate, incomplete, outdated, false, unlawfully obtained, or unauthorized use or disclosure of your Personal Information.
Should you feel that there has been mishandling or misuse of your Personal Information, or that any of your data privacy rights have been violated, you may email us at our details provided below.
- COLLECTION OF USER DATA
As part of our continuing relationship with you, we collect, process, use, and share your User Data in accordance with this Privacy Policy.
The User Data that we collect, process, use, and share are either Personal Information or Non-Personal Information:
-
Personal Information is any information from which the identity of an individual can be reasonably and directly ascertained, or when put together with other information would directly and certainly
identify an individual, such as name, gender, date of birth, address, telephone/mobile number, email address, proof of identification, etc.
-
Non-Personal Information is any information that does not identify you individually, and includes statistical or analytical data, geographical images and information, and anonymized or aggregated
reports.
- USE OF CUSTOMER DATA
- We may share User Data within SMSGMS or with partners, and third-party service providers as part of business operations and provision of products and services.
- Without limiting the generality of the foregoing, User Data is used to, among others:
- 2.1Provide you with the relevant services and offerings in the website, including user support;
- 2.2Help us improve the quality of our services;
- 2.3Create new products and services;
- 2.4Enhance your user experience and determine tailored content to meet your preferences and needs;
- 2.5Communicate relevant services and/or advisories/announcements to you;
- 2.6Abide by any safety, security, public service or legal requirements and processes;
-
2.7Process information for statistical, analytical, and research purposes. The use of your information for statistical, analytical, and research purposes enables us to create
anonymized and aggregated insight reports that we use to further improve your user experience and to provide new products and services;
-
2.8Create a user portrait based on your demographic, and your behavioral, transaction, and interaction data across all products, systems, devices, and/or interaction channels,
which we may use as a basis for sending you commercial and promotional alerts, personalized advertisements, financial service offers, and surveys. To be clear, should we need to share data with third
parties for advertising and marketing purposes, we only share anonymized and aggregated data, and not your Personal Information; and
-
2.9Comply with the requirements of the law and legal process, such as a court order; to comply with a legal obligation; or to prevent imminent harm to public security, safety,
or order, collectively referred to as “Data Use Purpose.”
When required by our Privacy Policy and the law, and before we collect, process, use, or share your Personal Information for any other purpose other than enumerated above, we will ask for your
consent.
When you use our website and electronically communicate with us, depending on your settings, we may use cookies, web beacons, small data text files, or similar technologies to identify your device
and record your preferences, with your consent. The completeness and accuracy of your Personal Information help us improve our products and services. Thus, we encourage you to update your Personal
Information from time to time.
We outsource or contract the processing of User Data to third parties, such as but not limited to vendors, service providers, partners, or telecommunications operators, to fulfill any of the above
purposes. They are only authorized to use User Data for such contracted purposes. They may have access to User Data for a limited time under reasonable contractual and technical safeguards to
limit their use of such User Data. We require them to protect relevant User Data, in a manner at least consistent with applicable privacy laws.
During roaming or when availing of services offered by foreign service providers through our network, the storage, treatment, and transfer of your Personal Information may be subject to
regulations different from Philippine regulations.
- PROTECTION OF PERSONAL INFORMATION
We respect your privacy. We take paramount care in protecting your Personal Information. As such, we secure and protect your Personal Information with proper safeguards to ensure confidentiality and privacy;
prevent loss, theft, or use for unauthorized purposes; and comply with the requirements of the law.
We regularly review our information collection, storage, and processing practices, including physical security measures, to guard against unauthorized access to our system and unauthorized alteration,
disclosure, or destruction of information we hold.
We only permit your Personal Information to be collected, processed, used, and shared by our authorized employees, contractors, and subcontractors who hold such Personal Information under strict
confidentiality and in accordance with their contractual obligations and who have implemented minimum security features against data leakage, unauthorized access, or disclosure. We restrict access to
information to SMSGMS employees, contractors, and subcontractors who need to know such information in order to process it for us, who are subject to strict contractual and technical safeguards, and who are
accountable to us if they fail to meet these obligations.
We only give you or your authorized representative access to your Personal Information. We do not provide, sell, or share your Personal Information to anyone unless you have given your express consent. We
also do not use nor share your Personal Information with content and/or information providers without your prior request or consent. Personal Information will only be disclosed to third parties in accordance
with this Privacy Policy.
We keep our records as accurate as possible. If your Personal Information is wrong, we give you ways to update it. Once you have submitted your User Data, you may correct your Personal Information submitted
by contacting us at our details provided below.
We keep your Personal Information in our business records, as may be applicable, as long as it is necessary to fulfill the purpose for which it was collected, or while it is needed by us for business, tax, or
legal purposes. When disposing of your Personal Information, we take reasonable measures to ensure that it is done properly and is not accessible to the public.
We are not responsible for information, content, application, product, or service that we do not provide. However, we will not tolerate the use of our network that violates the law, which shall include but
not be limited to:
-
Photo or video voyeurism, including the publication or broadcast or transmission through our network of any sexual act or any similar activity without the consent of the person involved and under
circumstances in which the person has a reasonable expectation of privacy, is prohibited and unlawful with corresponding penalties under the law;
-
Child pornography is also prohibited and punishable by law and our network shall not be used in any manner for the storage, transmission, or dissemination of materials containing child pornography. We
will report any instances of such activity that we become aware of, to the proper authorities as required by law.
We shall cooperate with law enforcement agencies to curtail criminality and prevent criminals from wreaking havoc over the internet, which shall include the blocking of certain sites or prevention of access
to certain individuals, all in accordance with the stipulations of the law and with respect to legal due process.
- CONTACT US
For any questions or concerns on your Personal Information or privacy rights, you may contact us through our Data Protection Officer as follows:
Email: dpo@smsgms.com
Contact No.: +632-8636-7499
Penthouse East Tower, Tektite Towers,
Exchange Road, Ortigas Center